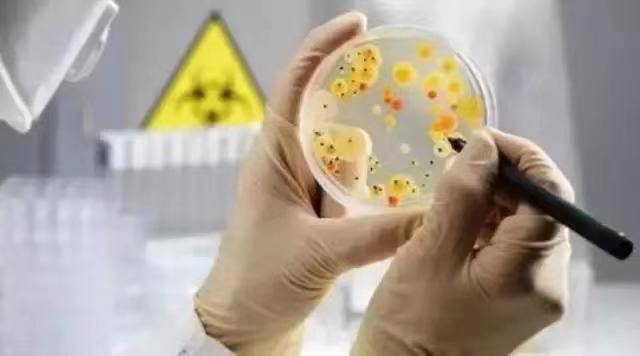
食品检测报告的重要性与频率 食品检测报告的重要性与频率

新闻动态
食品检测报告多久做一次
食品检测报告是确保食品安全和保护消费者健康的重要工具。通过对食品进行科学检测和分析,可以发现和预防各种食品安全问题,如有害物质、微生物污染和营养成分不足等。因此,定期进行食品检测是非常必要的。
食品检测报告的频率应根据食品的种类、质量、产地和供应链等因素进行评估。一般来说,食品安全风险较高的食品(如生肉、水产品和新鲜农产品)需要更频繁的检测,以确保其符合卫生标准。而对于加工食品和包装食品,检测频率可以相对较低,但仍需要定期进行。
根据国际食品安全标准和相关法规,食品检测报告的时间间隔可以根据不同食品的特性和风险评估结果来确定。一般而言,生鲜食品的检测应该是每批次或每一段时间进行,以确保食品的新鲜度和安全性。对于包装食品和加工食品,建议每隔3到6个月进行一次检测。
食品检测报告的实施机构应该是具备权威认证的食品检测实验室。这些实验室应该具备先进的仪器设备和专业的技术人员,能够进行准确、可靠的食品检测和分析。
食品检测报告不仅可以提供食品质量和安全的信息,帮助消费者做出明智的购买决策,还可以促进食品生产和供应链的改进和优化。通过检测报告,食品生产企业可以了解自身产品的质量情况,及时纠正不足,提升竞争力。同时,食品检测报告也是政府监管部门进行食品安全监管和执法的重要依据。
食品检测报告是确保食品安全和保护消费者健康的重要手段。根据食品的种类、风险评估和国际标准,定期进行食品检测是必要的。检测报告的可靠性取决于实施机构的权威性和专业性。通过食品检测报告,消费者可以了解食品质量和安全的情况,生产企业可以优化生产和供应链,政府监管部门可以加强食品安全监管。保护消费者的饮食安全,需要我们每个人共同的努力。
欢迎来电咨询-15635143639